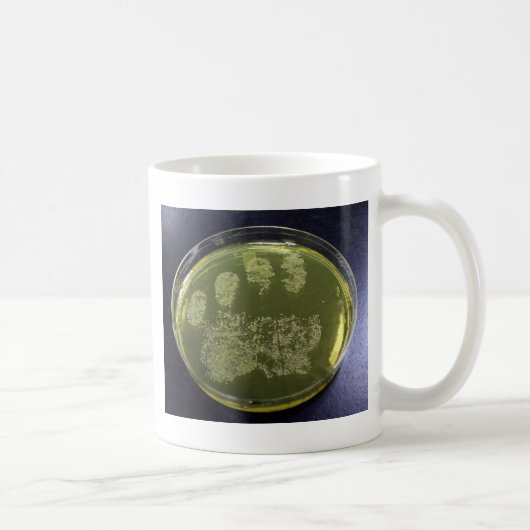
Mug Bactéries de boîte de Pétri de main (Droite)

Cartes de visite juridique et finance
Cartes de visite marketing et com
Cartes de visite sport et fitness
Cartes de visite beauté et soins
Cartes de visite BTP et artisanat
Cartes de visite restauration
Cartes de visite photographie
Cartes de visite santé et bien-être
A propos de Tasses
Vendu (e) par
À propos de ce design
Mug Bactéries de boîte de Pétri de main
Une photo de Staphylococcus aureus s'élevant d'un plat d'agar de sel de mannitol.
Traduction automatique
Avis des clients
4.8 sur 5 étoiles12 Nombres de Commentaires
12 Commentaires
Avis sur des produits similaires
5.0 sur 5 étoiles
5 sur 5 étoilesPar Hélène F.11 décembre 2022 • Achat sécurisé
Tasse blanche classique, 325 ml
Programme d'évaluation de Zazzle
C'est exactement ce que j'attendais. Belle qualité et parfaite impression. Je recommande à tous. Parfaite impression comme je l'avais commandée
5.0 sur 5 étoiles
5 sur 5 étoilesPar Perin v.22 septembre 2020 • Achat sécurisé
Combo mug, 325 ml
Programme d'évaluation de Zazzle
Surprise par le travail final. Le produit correspond à mes attentes. J’adore la couleur. Les collègues en sont jaloux. Peu au courant de ce genre de produit en lien avec les emojis, ils ont été tous surpris. Traits précis, les détails y sont. Très belle impression
5.0 sur 5 étoiles
5 sur 5 étoilesPar c.22 février 2021 • Achat sécurisé
Combo mug, 325 ml
Programme d'évaluation de Zazzle
Très bon et beau produit et service parfait. je suis complétement satisfait du produit
Tags
Autres infos
Identifiant du produit : 168388286556320374
Fabriqué le 24/12/2013 9:11
Évalué G